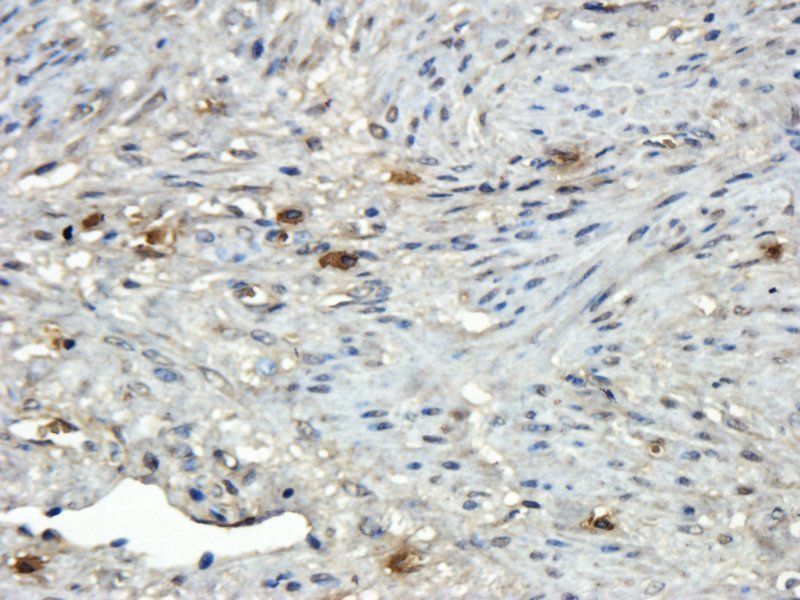
Reelin antibody

You have no items in your shopping cart.
All Products
- Featured

FC, IF, IHC-Fr, IHC-P, WB
Human, Mouse, Rat
Bovine, Drosophila, Porcine, Rabbit
Rabbit
Polyclonal
Unconjugated
1 ml, 100 μl, 500 μl, 200 μl - CD133 antibody [orb99113]Featured

ELISA, ICC, IF, IHC-P, WB
Human, Mouse, Rat
Rabbit
Polyclonal
Unconjugated
100 μg - tdTomato Antibody [orb182397]Featured

ELISA, FACS, IF, IHC-Fr, IHC-P, WB
Other
Goat
Polyclonal
Unconjugated
100 μg - Featured

FC, IF, IHC-Fr, IHC-P, WB
Human, Mouse, Rat
Bovine, Canine, Porcine
Rabbit
Polyclonal
Unconjugated
50 μl, 100 μl, 200 μl - CD31 antibody [orb10314]Featured

ELISA, ICC, IF, IHC-P, WB
Human, Mouse, Rat
Rabbit
Polyclonal
Unconjugated
100 μg